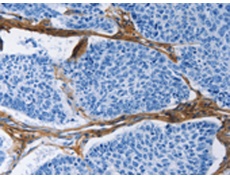
一抗

中文名稱:兔抗COL3A1多克隆抗體
|
Background: |
This gene encodes the pro-alpha1 chains of type III collagen, a fibrillar collagen that is found in extensible connective tissues such as skin, lung, uterus, intestine and the vascular system, frequently in association with type I collagen. Mutations in this gene are associated with Ehlers-Danlos syndrome types IV, and with aortic and arterial aneurysms. Two transcripts, resulting from the use of alternate polyadenylation signals, have been identified for this gene. |
|
Applications: |
ELISA, IHC |
|
Name of antibody: |
COL3A1 |
|
Immunogen: |
Fusion protein of human COL3A1 |
|
Full name: |
collagen, type III, alpha 1 |
|
Synonyms: |
EDS4A |
|
SwissProt: |
P02461 |
|
ELISA Recommended dilution: |
1000-5000 |
|
IHC positive control: |
Human lung cancer and human prostate cancer |
|
IHC Recommend dilution: |
50-200 |

 購物車
購物車 幫助
幫助
 021-54845833/15800441009
021-54845833/15800441009